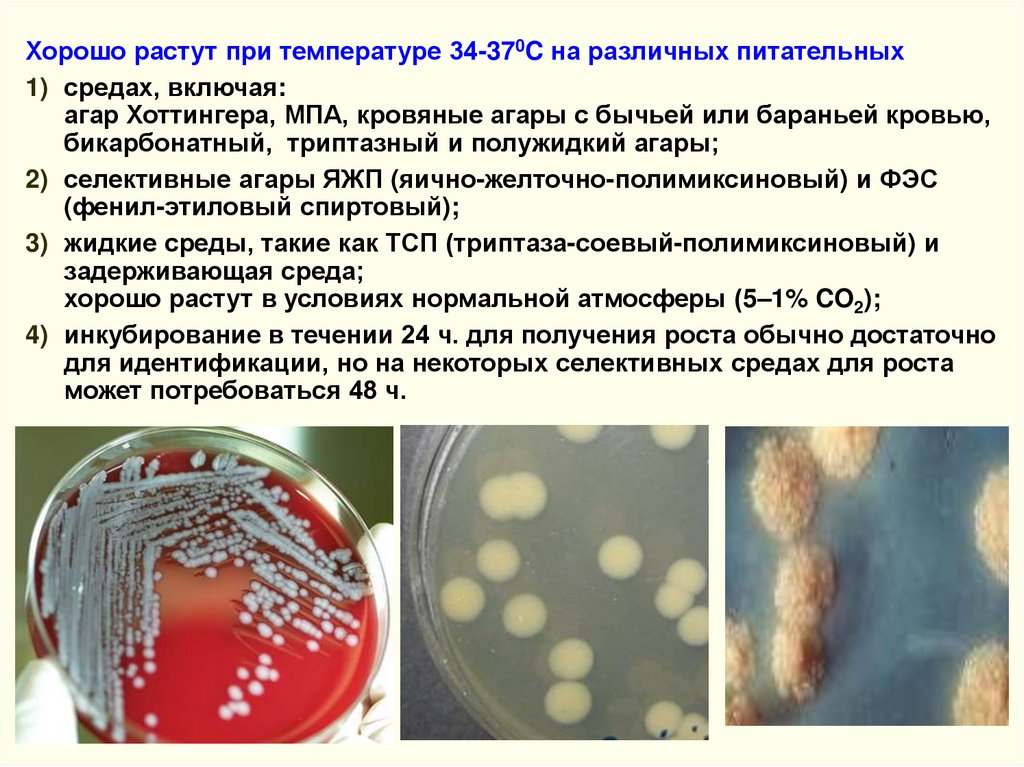
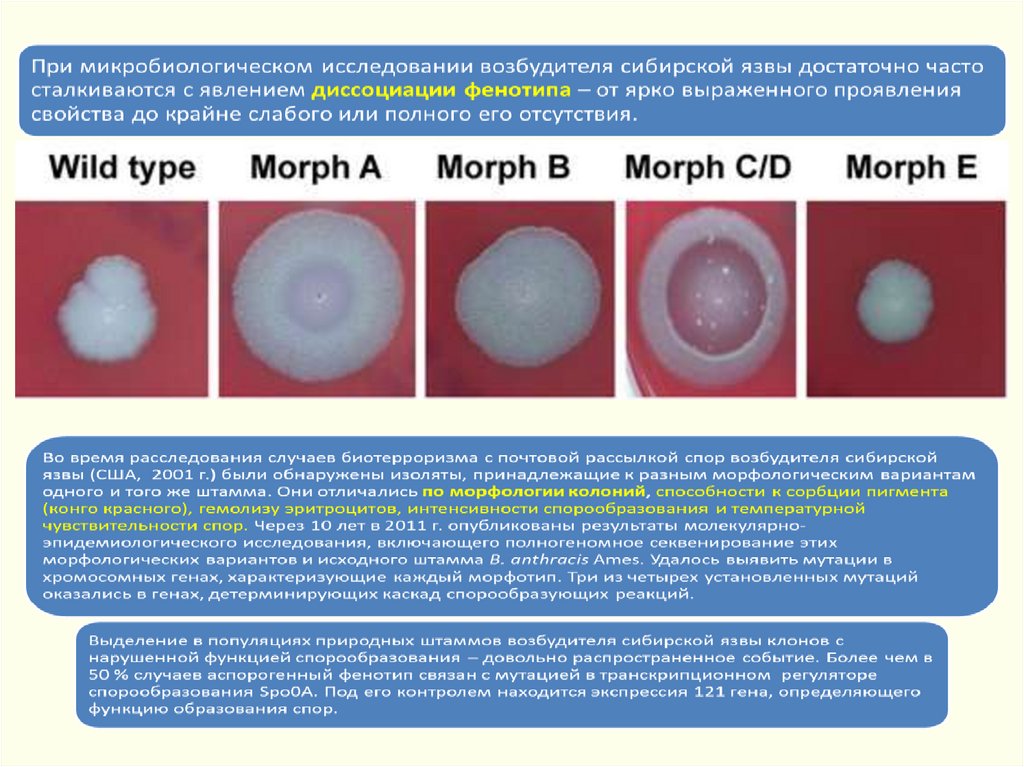
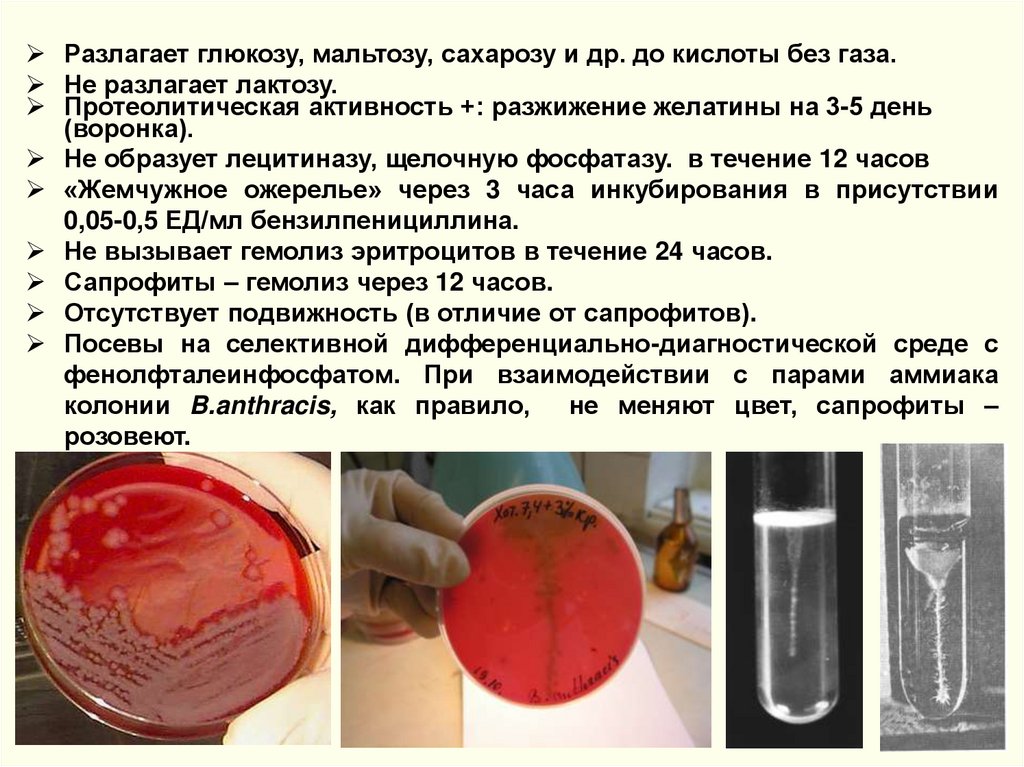
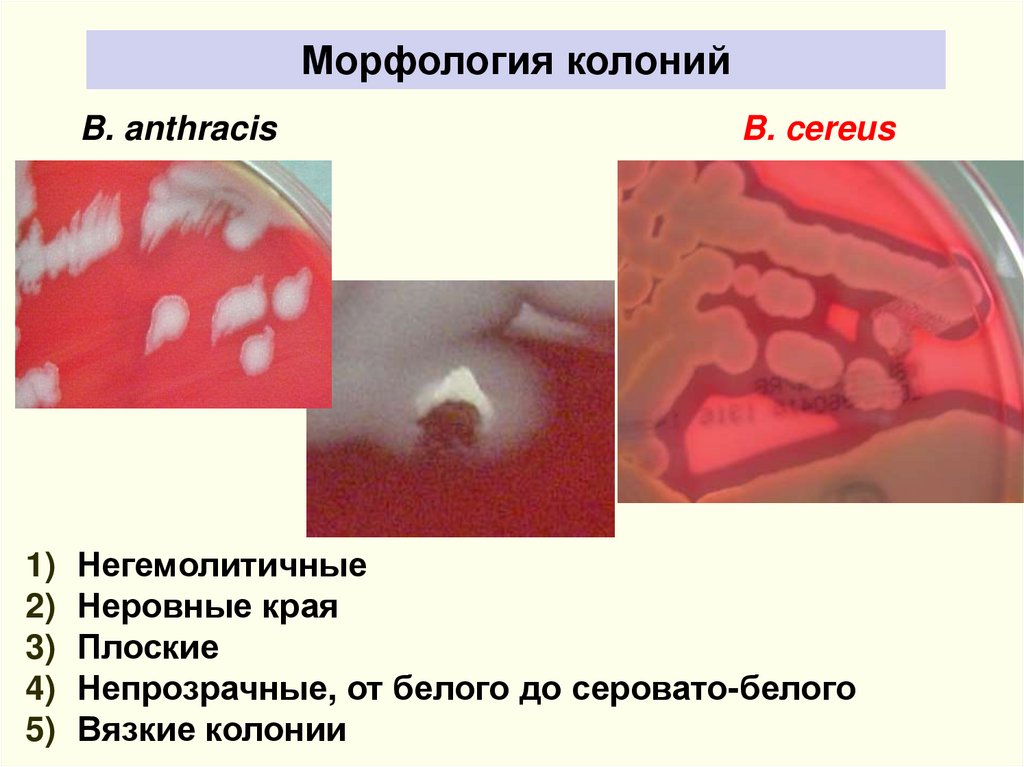

Similar presentations:
Сибирская язва
1.
СИБИРСКАЯ ЯЗВАЗав. каф. инфекционных болезней
Медицинский институт Ордена Трудового Красного Знамени
имени С.И. Георгиевского
ФГАОУ ВО «КФУ имени В.И. Вернадского»
д.м.н., проф. Каримов
Искандер
Загитович
2.
Сибирская язва – (карбункул злокачественный, Anthrax) – остраязоонозная, бактериальная антропургическая инфекционная
болезнь, характеризующаяся интоксикацией, развитием серозногеморрагического воспаления кожи, лимфатических узлов и
внутренних органов, протекающая в виде кожной или
септических форм.
Первое письменное описание сибирской язвы было дано в Книге
Бытия, где эта болезнь называется «египетской пятой казнью» (1491 до
н.э.), которая погубила скот в Египте.
Другие описания сибирской язвы, поражающей как животных, так и
людей, приводятся в ранних памятниках индийской, греческой, римской
и русской литературы.
В древности называли «священный огонь», «персидский огонь» и др.
В Европейских странах эпизоотии и эпидемии сибирской язвы
наблюдались 826 г, 992 г.,1682г. и позднее.
В России – летописях за 978,1158,1284 гг., частые вспышки в 14 и 18 вв.
Первые исследования России – Абрам Эшке (1758) и Никита
Ножевщиков (1762г. – описал кожную форму).
XII век – летописец писал о болезни, в результате которой в
Новгородском княжестве пал весь скот.
3.
ИсторияВ России была распространена в Сибири (1864-1866), отсюда
название СЯ.
В опытах самозаражения русский врач С.С. Андреевский (1788)
установил идентичность СЯ животных и человека, собственно,
он и дал название «СЯ».
В 1849-1850 гг. – возбудитель СЯ был описан Поллендером,
Брауэллем и Давеном.
1785 г. – в Сибири погибло 100 тыс. лошадей.
1876 г. – Р.Кох выделил СЯ в чистой культуре.
1880 г. – первое сообщение о СЯ человека сделано в СПетербурге гл. врачом Обуховской больницы Германом.
1881 г. – Пастер предложил живую вакцину, но в связи с
монополизацией Л.С.Ценковский создал отечественную живую
вакцину.
1880-х гг. Англия, Германия – первые сообщения о вспышках,
связанных с профессиональным инфицированием сибирской
язвой (кожные и легочные формы).
1902 г. – Асколи разработал диагностическую реакцию
преципитации, используемую сегодня.
4.
1904 г. – на строительстве Уссурийской железной дороги за 2 недели отСЯ пало 2000 лошадей, погибло 30 человек, остальные рабочие в
панике разбежались.
1905-1914 гг. – СЯ в России заболело 157 936 чел.
1910-1920 гг. во Франции: – 405 случаев, в Германии – 1700.
1944 г. – Широкое практическое применение вакцины СТИ (санитарнотехнологический институт), предложенной Н.Н. Гинзбургом и А.Л.
Тамариным.
1956г. – С.Г. Колосов, Н.А.Михайлов, Ю.Ф. Борисович предложили
гидроокисьалюминевую вакцину (ГНКИ — Государственный научноконтрольный институт ветеринарных препаратов).
1979 г. – утечка боевых штаммов в Свердловской области, погибло
66/77 человек.
1970-1990 гг. – в Камбоджии, Афганистане (в/сл).
1992-1995 гг. – (по 55 случаев ежегодно). Карачаево-Черкесия – в 2
аулах заболело 21, из которых у 1 – генерализованная форма.
Август 1995 г. – в Тамбовской области заболело 3 чел. от мяса коровы,
мясо которой и еще 4-х коров было отправлено, на мясокомбинат, а
продукция населению Московской и Владимирской области.
США – 2003 г. умышленное заражение людей боевым штаммом СЯ
обиженным сотрудником Пентагона, тогда заболело 23 человека,
погибло - 5 человек.
5.
6.
ЭТИОЛОГИЯ. Возбудитель – Bacillus anthracis – Гр+ палочка до 10нм, факультативный аэроб, растет при 37° на средах с
аминокислотами в виде «кружевных платков», в мазках
располагается парами, цепочками, в одиночку.
Встречается в 2 формах: бациллярной (вегетативной) и споровой.
Вегетативные формы малоустойчивы – при 55° погибают через 40
мин., при кипячении – мгновенно, дез. средства убивают их за
несколько минут. В трупах погибают через 2-7 дней.
ТАКСОНОМИЯ
Подцарство – Bacteria. Тип – Firmicutes. Класс – Bacilli.
Порядок – Bacillales. СЕМЕЙСТВО – BACILLACEAE.
ОТРЯД – EUBACTERIALIS. РОД – BACILLUS. ВИД – 263 вида,
в том числе:
близкородственные B.cereus, B.anthracis, B.thuringiensis,
B.mycoides.
новые B.weihenstephanensis, B.manliponensis
7.
Bacillus anthracis: генетикаB.mycoides
B.weihenstephanensis
8.
9.
Грамположительная палочка 6-10 мкм - 1,0-1,5 мкм.Жгутиков нет.
Капсула при 37°С в живом организме или на специальных
питательных средах.
Спора – овальная, центрально расположена, не превышает
диаметр тела клетки – 0,8-1,0 мкм – 1,2-1,5 мкм.
Аэроб или факультативный анаэроб (предпочитает расти при
доступе кислорода, но может и без).
Температурный оптимум роста – 34-37°С (12-43°С).
pH среды – 7,2-7,5.
R- или SM-форма роста на питательных средах.
В мазках:
из патологического материала: поодиночке, попарно,
короткие цепочки, окруженные капсулой (иногда капсула на
группу клеток).
из культур, выращенных на питательных средах: длинные
цепочки, края обрублены («бамбуковая трость» с
коленчатыми соединениями).
10.
Хорошо растут при температуре 34-370C на различных питательных1) средах, включая:
агар Хоттингера, МПА, кровяные агары с бычьей или бараньей кровью,
бикарбонатный, триптазный и полужидкий агары;
2) селективные агары ЯЖП (яично-желточно-полимиксиновый) и ФЭС
(фенил-этиловый спиртовый);
3) жидкие среды, такие как ТСП (триптаза-соевый-полимиксиновый) и
задерживающая среда;
хорошо растут в условиях нормальной атмосферы (5–1% CO2);
4) инкубирование в течении 24 ч. для получения роста обычно достаточно
для идентификации, но на некоторых селективных средах для роста
может потребоваться 48 ч.
11.
SM-форма роста B.anthracisКолонии крупные, гладкие, блестящие, влажные, слизистые, неровным
краем, плохо снимающиеся с поверхности агара.
Диффузное помутнение бульна с придонным ростом в виде «комочка
ваты», трудно разбивающегося при встряхивании.
12.
13.
14.
Вне организма человека и животного при доступе кислорода извегетативных клеток образуется спора.
Споры чрезвычайно устойчивы – в почве сохраняются
десятилетиями, после 5-10 минутного кипячения вегетируют,
под действием сухого жара при 120-140° погибают через 1-3 ч.,
в автоклаве при 130°С – через 40 мин., под действием 1%
формалина и 10% едкого натра – через 2 часа.
Вегетативная форма образует капсулу. Термолабильный
экзотоксин играет ведущую патогенетическую роль.
1 – капсульный Аг, подавляет фагоцитоз. Ат к нему не проявляют
защитного действия.
2 – соматический Аг, Ат к нему не проявляют защитного действия.
3 – токсин, через 18-20 ч. инкубирования. Взаимодействует с
мембранами клеток и опосредует проявление активности других
компонентов; летальный фактор – проявляет цитотоксический
эффект и вызывает отек легких; развитие отеков.
Разработаны СЯ анатоксины, но их структура и механизмы
действия изучены не полностью, а если откровенно –
засекречены.
15.
ЭКЗОТОКСИН1) Ведущая роль
иммунитет.а
в
патогенезе
и
формировании
специфического
2) Являются бинарными двухкомпонентными белковыми токсинами АВтипа и обладают двумя видами биологической активности.
3) Компоненты токсина: протективный антиген (ПА, 89 кДа), отечный
фактор (ОФ, 83 кДа), летальный фактор (ЛФ, 85 кДа).
4) ПА
–
общая
субъединица
(В)
токсинов,
взаимодействие субъединиц А (ОФ или ЛФ)
рецепторами.
обеспечивающая
с клеточными
5) Токсин отечный = ПА+ОФ; Токсин летальный = ПА+ЛФ.
ПРОТЕКТИВНЫЙ АНТИГЕН – ПА
Включает 4 функциональных домена с различными функциями:
1-й — содержит протеолитические ферменты, которые отщепляют от ПА
концевой фрагмент, а оставшаяся часть обеспечивает
проникновение ОФ и ЛФ в клетку.
2-ой — его активная зона формирует поры.
3-й — гидрофобная часть участвует во взаимодействии с ОФ и ЛФ.
4-й — отвечает за закрепление токсина на специфическом рецепторе
клетки-мишени.
16.
17.
Основные факторы патогенностихромосома
pXO1
экзотоксин
pXO2
капсула
18.
Капсула B.anthracisТипичные
вирулентные
штаммы
образуют
капсулу
при
культивировании
на
1%
бикарбонатном агаре в атмосфере с 5-50% СО2.
или на жидкой среде ГКИ (40% инактивированной
бычьей/лошадиной сыворотки и 60% среды
Хенкса).
Капсульное вещество не обладает пирогенными,
иммуногенными и токсигенными свойствами.
19.
Капсула B.anthracis1)
2)
3)
Препятствует опсонизации и фагоцитозу бацилл
Способствует фиксации к клеткам макрофагальной системы
хозяина.
При деполимеризации за счет собственного фермента
B.anthracis освобождается вещество, необходимое для
размножения возбудителя in vivo.
Играет решающую роль в диссеминации микроба при
ингаляционном заражении.
Синтез кодируется плазмидой рХО2.
Утрата способности к продукции капсулы приводит к потере
вирулентности.
Содержит 3 антигенных комплекса:
Поверхностные
Собственнокапсульные
Антигены оболочки клетки
20.
Геном B.anthracisКольцевая хромосома (5200 т.п.н.). Только 150 существенных
различий меду генами B.cereus и B.thuringiensis. Однако ряд
локусов высоко специфичны и являются ДНК-мишенями при
разработке тест-систем.
Плазмида рХО1 (181,7 т.п.н.). Содержит «остров патогенности»,
включающий три структурных гена токсинов, регуляторные
гены, три гена оперона прорастания спор и 19 ОРС. 90%
гомологии ДНК с двумя штаммами B.cereus и
штаммом
B.thuringiensis.
Плазмида рХО2 (94-96 т.п.н.). Содержит оперон биосинтеза
капсулы, ген деполимеризации капсульного пептида и
регуляторные гены. Ген atxA (рХО1) участвует в координации
синтеза капсулы.
B.anthracis – один из наиболее генетических мономорфных
микроорганизмов.
21.
Bacillus anthracis: geneticsГеном B. anthracis
Хромосома
Токсины
B.anthracis
Капсула
22.
23.
1) Белок, кодируемый геном ger X – для прорастания спор in vivo.2) Ферритин-подобные белки (сидерофоры), связывающие железо, и
фосфолипазы.
3) Два белка S-слоя Sap и EA1.
4) Автоиндуктор сигнальных молекул «чувства кворума».
5) Транскрипционный фактор общего стресса.
6) Аутолизин.
7) Антролизин О (холестерин-зависимый цитолизин).
8) Антрализины (гемолизины).
24.
25.
26.
27.
28.
29.
Спора B.anthracis1 – кортекс
2 – оболочка
3 – спороплазма
Споры являются основным
фактором поддержания
циркуляции инфекции
30.
Спора B.anthracis1 – экзоспориум
2 – оболочка споры
3 – кортекс
4 – спороплазма
5 – оболочка цитоплазмы
31.
32.
Разлагает глюкозу, мальтозу, сахарозу и др. до кислоты без газа.Не разлагает лактозу.
Протеолитическая активность +: разжижение желатины на 3-5 день
(воронка).
Не образует лецитиназу, щелочную фосфатазу. в течение 12 часов
«Жемчужное ожерелье» через 3 часа инкубирования в присутствии
0,05-0,5 ЕД/мл бензилпенициллина.
Не вызывает гемолиз эритроцитов в течение 24 часов.
Сапрофиты – гемолиз через 12 часов.
Отсутствует подвижность (в отличие от сапрофитов).
Посевы на селективной дифференциально-диагностической среде с
фенолфталеинфосфатом. При взаимодействии с парами аммиака
колонии B.anthracis, как правило, не меняют цвет, сапрофиты –
розовеют.
33.
Чувствительность к бактериофагамB.anthracis лизируется сибиреязвенными
фагами «Гамма», «К», Fah-ВНИИВВиМ.
Посевы просматривают под малым
увеличением микроскопа, а через 12-24 часа –
невооруженным глазом.
Для идентификации методом нарастания
титра фага можно использовать тест
набор «Оболенск R1»
34.
Эпидемиология.Интенсивные очаги – в Азии, Ю.Африке, Ю.Америке, Австралии,
спорадические случаи – в Европе, России, США. Ежегодно СЯ
заболевают около 1 млн. животных и регистрируют 40 тыс. случаев
среди людей.
Источник – больные животные, в основном крупный и мелкий
рогатый
скот,
лошади,
верблюды,
свиньи
(болеют
генерализованной формой), отмечены случаи среди зайцев, кошек
и собак). У человека
заболевание носит выраженный
профессиональный характер.
Три типа очагов: 1) профессионально-сельскохозяйственный,
2) профессионально-индустриальный, 3) бытовой.
У животных – чаще кишечная и септическая формы (летальность
80%).
Путь заражения – контактный, пероральный, аэрогенный.
Возможно – кровососущими насекомыми.
Случайная СЯ – во время ношения головных уборов и полушубков.
Во время русско-японской войны – 976 случаев от папах и
полушубков. Предполагают – при пользовании пальмовыми
мочалками (люффы).
35. Распространение сибирской язвы в мире
36. Заболеваемость сибирской язвой в РФ за 1980 – 2010 гг.
80127
16%
70
60
50
260
32%
40
30
20
10
0
421
52%
Число случаев сибирской язвы в 1980-1989 гг.
Число случаев сибирской язвы в 1990-1999 гг.
Число случаев сибирской язвы в 2000-2010 гг.
37. На территории Российской Федерации
более 35 тысяч стационарнонеблагополучных по сибирской язве
пунктов
1.
2.
3.
зона спорадических проявлений (севернее 560 с. ш.)
периодических проявлений (56 - 530 с. ш.)
устойчивых проявлений (южнее 530 с. ш.)
38.
Цикл развития возбудителя сибирской язвывегетативная форма
B. anthracis
герминация
споруляция
почва
В течение всего времени нахождения в
почве споры возбудителя сибирской
язвы представляют собой
потенциальный источник инфекции для
восприимчивых животных. Попадая в
организм преимущественно травоядных
животных, споры превращаются в
вегетативные формы, вызывающие
инфекционное заболевание.
споры
Для человека даже в районах с
высокой контаминацией почвы
возбудителем сибирской язвы риск
инфицирования практически
отсутствует. Это объясняется
образованием относительно крупных
(более 6 мкм) агрегатов спор с
компонентами почвы, в результате они
теряют способность проникать в
терминальные отделы дыхательных
путей.
39.
Источники инфекции: домашние и дикие травоядные животные(крупный и мелкий рогатый скот, лошади, ослы, олени, верблюды,
свиньи и др.), нередко и плотоядные животные.
Резервуар: почва. Значительную эпизоотическую и эпидемическую
опасность представляют сибиреязвенные скотомогильники.
Больной человек эпидемиологической опасности не представляет
(кроме больных лёгочной формой).
Механизм передачи: преимущественно контактный. Аспирационный и
трансмиссивный механизмы передачи возбудителя реализуются
воздушно-пылевым и инокуляционными путями передачи. Заражения
пищевым путем при употреблении термически необработанных
мясопродуктов.
40.
контаминированные возбудителем участки почвы, пастбища, водоёмы«ПРОКЛЯТЫЕ ПОЛЯ»
41. Основные пути распространения сибирской язвы среди животных и людей
42. Новые пути распространения особо опасных инфекционных болезней Завоз и вспышки сибирской язвы в 2009-2013гг. на путях
распространения наркотиков:Шотландия - 47 заболевших
(13 погибших)
Англия – 4 заболевших (3
погибших)
Германия - 2 заболевших (1
погибший)
В 2012 году выявлено 13
случаев заболевания
инъекционной формой
сибирской язвы (5 с
летальным исходом): 6
человек - в Великобритании,
4 в Англии (3 летальных), по
одному - в Шотландии и
Уэльсе; 4 случая в Германии
(1 летальный), 2 - в Дании (1
летальный), 1 - во Франции.
Результаты идентификации и
молекулярного типирования
выделенных штаммов B. anthracis
Штамм B. Anthracis азиатского происхождения
(Б.Восток, Афганистан).
Природный штамм с обычными параметрами
устойчивости к антибиотикам
Е.В. Гаврилин, ВОЗ, Координатор лабораторных сетей, Биобезопасность и биозащита
43. Сибирская язва как биологическое оружие
Свердловск, 1979 (СССР)– 120 до >400 людей заболели, приблизительно 75 из них
умерли.
– Результаты вскрытия выявили геморрагический менингит и
медиастенит
– Позднее инфекцию связали с утечкой аэрозоля с
биологическим оружием и лаборатории
– Болезнь распространилась по направлению ветра
Anthrax Deaths. Свердловск - смертность в
результате СЯ
44.
45.
Патогенез.1) Внедрение возбудителя ч/з кожные покровы и размножение.
2) Проникновение и размножение в регионарных лимф/узлах
(медиастинальные и брызжеечные лимфоузлы), куда он
заносится макрофагами (в результате незавершенного
фагоцитоза).
3) Если иммунная система не справляется с возбудителем, то
преодолевая барьер лимфоузлов развивается септицемия с
различной очаговостью.
4) Отмечается стойкая бактериемия, тяжелая интоксикация, ИТШ,
тромбогеморраги-ческий
синдром,
полиорганная
недостаточность.
5) В местах локализации возбудителя – серозно-геморрагическое
воспаление с резчайшим отеком, некрозом тканей.
6) На вскрытии – выраженное полнокровие внутренних органов,
кровь не сворачивается.
7) Характерный признак СЯ сепсиса – геморрагический
менингоэнцефалит (при вскрытии – «кардинальская шапочка».
Иммунитет стойкий, однако, возможно заражение после
перенесенной легкой формы или вакцинации (давно).
46. Сибирская язва (A22) МКБ-10
Сибирская язва (A22)– A22.0
– A22.1
– A22.2
– A22.7
– A22.8
– A22.9
МКБ-10
Кожная форма сибирской язвы:
Злокачественный(ая): карбункул. Пустула.
Легочная форма сибирской язвы.
(Респираторная форма сибирской язвы,
Болезнь тряпичников,
Болезнь сортировщиков шерсти).
Желудочно-кишечная форма сибирской
язвы.
Сибиреязвенная септицемия.
Другие формы сибирской язвы:
Сибиреязвенный менингит+ (G01*)
Сибирская язва неуточненная.
47.
Клиника.Инкуб. период – от нескольких часов до 14 дней, чаще 2-3 дня.
1. Локализованная (кожная) форма. (98-99%)
2. Генерализованная (септическая) форма.
Наиболее частой разновидностью локализованной Ф. является
карбункулезная форма, реже встречаются эдематозная,
буллезная
и
эризепилоидная
(ранее
называлась
рожистоподобной).
Поражается: голова 30%, шея – 10%, туловище – 2,5%,
в.конечности – 56%, н.конечности – 1,5%.
Обычно карбункул бывает один, но иногда - до 10-20 и более.
На месте входных ворот развивается пятно, папула, везикула,
язва.
Образуются дочерние пузырьки («жемчужное ожерелье»
корона Шоссье), обусловливающие эксцентрической рост язвы
(диаметр несколько миллиметров – 8-10 см). Трансформация за
несколько часов. Увеличение язвы происходит до 5-6 дня
болезни.
48.
Характерные черты карбункула (через сутки):Отсутствие болезненности в зоне некроза,
Обширный отек со студневидным дрожанием (симптом
Стефановского),
Регионарный лимфаденит, могут увеличиваться и отдаленные
лимфоузлы с отсутствием болезненности и медленным
обратным развитием (до 4 недель),
Вокруг язвы гиперемия кожи, особенно выражена при
локализации язвы на лице. Возникающий по периферии
карбункула отек тканей иногда захватывает большие участки с
рыхлой подкожной клетчаткой.
49.
• Плотное пятнышко в месте внедрения возбудителя50.
51.
52.
53.
54.
55.
56.
57.
58.
• На веках, шее, передней поверхности грудной клетки (развитаподкожная клетчатка) может быть резкий отек и вторичный
некроз, образующиеся там пузыри с серозно-геморрагическим
экссудатом вскрываются, омертвевшие ткани имеют четкую
демаркационную линию, затем образуется струп со всеми
стадиями развития.
59.
• Обычно возникает одна язва, но может быть 2-5 (даже 36).• Множественные язвы
60.
• Язва на лице61.
Редкие формы:Эдематозная – обширный отек без наличия карбункула, затем –
пузыри и обширные некрозы с формированием струпа.
Буллезная форма – пузыри с геморрагическим экссудатом,
вскрываются через 5-7 дней с развитием язв; выражена
интоксикация, лихорадка.
Эризипелоидная – беловатые пузыреи с прозрачной
жидкостью на припухлой, покрасневшей, безболезненной коже,
вскрываются через 3-4 дня, образуются множественные язвы,
неглубокие, быстро подсыхающие, формируется струп.
Септическая (генерализованная) форма СЯ встречается редко.
Начинается остро – озноб, повышения Т/тела до 39-40С.
Отмечаются: выраженная тахикардия, тахипноэ, одышка, боли
и чувство стеснения в груди, кашель с выделением пенистой
кровавой мокроты.
Рентгенологически – пневмония и выпотной плеврит.
Мокрота – вкрови и мокроте – большое количество СЯ
бактерий.
Степень физикальных данных (аускультативные и перкуторые)
первышают степень интоксикации.
62.
ЯМАЛ63.
64.
65.
66.
67.
68.
69.
70.
71.
72.
73.
74.
75.
76.
77.
78.
79.
Сибирская язва: Легочная/Медиастинальная форма80.
• Генерализованная форма. Поражениеинтратрахеальных лимфоузлов.
81.
• Генерализованная форма. Крупноочаговыесубарахноидальные кровоизлияния и
кровоизлияния в вещество мозга.
82.
83.
84.
85.
86.
87.
88.
Ж - ва Сания, 51 год, домохозяйка, владелица фермы Комсомол, точка Аккошар. Диагноз: сибирская язва, локализованная форма,
сибиреязвенный карбункул 5 пальца правой кисти, легкое течение.
Зуд в области мизинца правой кисти 17.08.05,
21.08.05 головная боль, тошнота, озноб. 21.08.05.
увидела „пузырек” на красном фоне на мизинце,
23 везикула стала темной, увеличилась в
размере, 24.08. язва темного цвета, вокруг нее
отек кожи. ,
15.08.05. занималась прирезкой заболевшего
бычка, имела контакт с мясом, внутренними
органами, кровью.
В семье 7 человек, кроме больной кожные
изменения у 12-ти летнего Бай- на А.,
проживающего в этой же семье. Все остальные
члены семьи здоровы. Антраксиновая проба
резко положительная.
Фото от 24.08.05
Фото от
26. 08. 05
Фото от
28.08.05
89.
Лабораторная диагностика.1. Бактериологическое и бактериоскопическое отделяемого из
карбункула, кровь, моча, кал, мокрота, рвотные массы.
2. Биологическая проба.
3. Серологическое исследование – с 5 дня болезни – РСК, РНГА,
ИФА.
4. Кожная проба с антраксином (реакция ГЗТ) – при эпид.
исследованиях.
5. Реакция Асколи – при отрицательных результатах бак.
исследования.
6. Лизабельность бактериофагом – с помощью бактериофагов
«ВА- 9» и «Саратов». Об. анализ крови – практически не
изменяется !!!
БАКТЕРИОСКОПИЧЕСКИЙ
БАКТЕРИОЛОГИЧЕСКИЙ
БИОЛОГИЧЕСКИЙ
ИММУНОЛОГИЧЕСКИЙ
АЛЛЕРГИЧЕСКИЙ
МОЛЕКУЛЯРНО-ГЕНТИЧЕСКИЙ
90. Нормативно-методические документы
СП 1.3.3118-13 «Безопасность работ с микроорганизмами I-IIгрупп патогенности (опасности)».
СП 1.2.036-95 «Порядок учета, хранения, передачи и
транспортирования
микроорганизмов
I-IV
групп
патогенности».
СП 3.1.7.2629-10 «Профилактика сибирской язвы».
МУК 4.2.2413-08 «Лабораторная диагностика и обнаружение
возбудителя сибирской язвы».
МУК 4.2.2941-11Порядок организации и проведения
лабораторной диагностики сибирской язвы для лабораторий
территориального, регионального и федерального уровней.
Практическое
руководство
«Лабораторная
диагностика
опасных и особо опасных инфекций», 2013.
91.
Лабораторныеисследования
клинического,
патологоанатомического
и
полевого
материала,
при
подозрении на сибирскую язву, проводят лаборатории,
имеющие разрешительную документацию на работу с
материалом, зараженным или подозрительным на заражение
микроорганизмами II группы патогенности.
Все работы с материалом, подозрительным на заражение
возбудителем
сибирской
язвы,
включая
забор,
транспортировку и подготовку материала для исследований,
проводятся в соответствии с действующими нормативнометодическими документами, регламентирующие деятельность
с возбудителями I-II групп патогенности.
Манипуляции с B.anthracis в боксах микробиологической
безопасности III класса.
92.
Материал для исследований:1. содержимое везикул, отделяемое карбункула или язвы, струпья,
2. мокрота,
3. кровь,
4. спинномозговая жидкость,
5. моча, испражнения,
6. Экссудаты,
7. секционный материал: кровь, экссудаты, кусочки органов (селезенки,
печени, лимфоузлов и другие);
8. материал от домашних, диких и лабораторных животных;
9. продовольственное сырье и продукты животного происхождения;
10. объекты окружающей среды - почва, трава, фураж, подстилка, вода и
другие.
Забор материала от больных (подозрительных на заболевание) людей
должен производиться до начала специфического лечения.
93.
Окраска по Граму B. anthracisКровь
Агаровая
культура
(отд. клетки или
короткие цепи)
CSF
Бульонная
культура
(длинные цепи)
94.
Прямая иммунофлуоресценцияФИТЦ - меченые антитела
95.
96.
• ИНДИКАЦИЯ• ИДЕНТИФИКАЦИЯ
Морфология
ОПОРНЫЕ ТЕСТЫ:
клеток
Морфология
колоний
Окраски по ГрАМУ
МФА
ПЦР
1) ПРОБА С Б/Ф
2) ТЕСТ «ЖЕМЧУЖНОЕ
ОЖЕРЕЛЬЕ»
3) КАПСУЛООБРАЗОВАНИЕ
4) МОРФОЛОГИЯ КОЛОНИЙ
5) МИКРОСКОПИЯ
6) РЕАКЦИЯ Асколи
97.
Лизис гамма фагамиB. Anthracis - мало или нет роста на
инокулированном участке
Другие виды Bacillus - сплошной рост
98.
РЕАКЦИЯ АСКОЛИ1) Реакцию ставят в уленгутовской пробирке.
2) Для этого в нее вносят 0,2-0,3 мл прозрачной
преципитирующей
сибиреязвенной
сыворотки и затем осторожно наносят
равное
количество
специально
подготовленного (горячий или холодный
способ) экстракта пробы.
3) При положительной реакции через 10-12
минут на границе соединения компонентов
обнаруживают характерный серовато-белый
диск (преципитирующее кольцо).
99.
Морфология колонийB. anthracis
B. cereus
1) Негемолитичные
2) Неровные края
3) Плоские
4) Непрозрачные, от белого до серовато-белого
5) Вязкие колонии
100.
ПодвижностьB. cereus
подвижны
B. anthracis
неподвижны
101.
Предварительная идентификация102.
Подтверждающая идентификацияИзолят
Лизис
фагами
ПИФ
Лошадиная кровь
(окраска М’Фадиена)
Бикарбонатная среда
(окраска М’Фадиена
Окраска тушью
103.
Применение ПЦР для выявления ДНК сибиреязвенногомикроба
1 этап
ДНК
pagA
2 этап
ГенСибТест-система для выявления ДНК Bacillus
anthracis (pXO1+) методом ПЦР»
ТУ 8895-007-01898109-2007
154 п.н.
104.
Идентификация Bacillus anthracis спомощью мультилокусной ПЦР
pagA
capB
Размер ампликона
Размер ампликона
214 п.н.
104 п.н.
105.
pPstpFra
pCad
Y. pestis
Мультилокусная ПЦР для одновременного
выявления ДНК возбудителей чумы,
туляремии и сибирской язвы
F. tularensis
B. anthracis
pXO1
pXO2
Локус 41,7 т.п.н.
Ген белка 23 Кда
pagA
Размер ампликона
Размер ампликона
Размер ампликона
177 п.н.
268 п.н.
368 п.н.
106.
БИОЧИПЫДНК-микрочип с зондами на гены 16S и
23S рРНК бактерий рода Bacillaceae
[Bavykin et al. 1999].
ДНК- и белковый чип для выявления
возможных агентов биотерроризма –
B.
anthracis,
F.
tularensis
и
Y. pseudotuberculosis (как прототип
чумного микроба) в пробах крови
[Tomioka et al., 2005, Huelseweh et al.,
2006].
Белковый чип с моноклональными
антителами к пептидам 23 и 43 кДа для
выявления возбудителя туляремии
[Jiang et al., 2005].
107.
108.
109.
110.
Автономная Система Детекции Возбудителей инфекционныхболезней - APDS (от англ. - Autonomous Pathogen Detection System
111.
Предварительные результаты специфической индикацииПри исследовании патологического материала от людей и
животных:
- через 2 – 6 ч, по результатам микроскопии и МФА с капсульносоматической люминесцирующей сывороткой;
- через 8 – 12 ч, по результатам ПЦР;
- через 2 – 6 ч, по результатам реакции преципитации по Асколи.
При исследовании секционного материала от трупов людей и
животных, а также кож, шкур, шерсти, мяса и мясопродуктов:
- через 2 – 6 ч, по результатам реакции преципитации по Асколи;
- через 2 – 6 ч, по результатам МФА с антиспоровой
люминесцирующей сывороткой;
- через 8 – 12 ч, по результатам ПЦР.
При исследовании материала из объектов внешней среды:
- через 2 – 6 ч, по результатам МФА с антиспоровой
люминесцирующей сывороткой;
- через 2 – 6 ч, по результатам РИГА;
- через 8 – 12 ч, по результатам ПЦР.
112.
Окончательные результаты идентификацииПри исследовании любого материала, подозрительного на зараженность
возбудителем сибирской язвы через 2–10 сут на основании:
1) морфологии колоний, характер роста на питательных средах
2) морфологии клеток в мазках из выросших подозрительных
3) колоний,
4) патоморфологической картины у павших или умерщвленных на 2 – 3
сутки белых мышей, обнаружения капсулы в мазках-отпечатках,
морфология колоний и культуральные свойства;
5) характера роста колоний на 1%-ном бикарбонатно-сывороточном агаре
и морфологии клеток в мазках, приготовленных из колоний или взвеси
микробов, выросших на жидкой среде ГКИ;
6) теста с сибиреязвенным бактериофагом;
7) теста на щелочную фосфатазу;
8) результатов теста на гемолиз на агаре с дефибринированной кровью
барана;
9) теста на лецитиназу;
10) теста на подвижность;
11) результатов теста “жемчужного ожерелья”;
12) результатов аллергической реакции с антраксином (через 24 и 48 ч);
13) результатов МФА (непрямой метод) с сывороткой больного.
113. Лаборатории территориального уровня
Лаборатории медицинских учрежденийДля
отбора
материала
на
сибирскую
язву
в
бактериологических лабораториях должна быть в наличии
укладка универсальная для забора материала от людей и из
объектов окружающей среды для исследования на ООИ и
СИЗ.
Производят отбор клинического материала от лиц с
подозрением на сибирскую язву, больных с любыми формами
болезни и секционного материала при летальном исходе.
Не
проводят
бактериологические
диагностические
исследования материала от больных с подозрением на
сибиреязвенную инфекцию.
Материал направляют в ФБУЗ «ЦГиЭ» в субъекте Российской
Федерации или противочумные учреждения.
114.
Лаборатории территориального уровняЛаборатории филиалов ФБУЗ «ЦГиЭ» в муниципальном
образовании в субъекте РФ
При осуществлении эпиднадзора и по эпидпоказаниям
проводят забор материала из объектов окружающей среды
(почва,
трава,
фураж,
подстилка,
вода
и
т.д.),
продовольственного
сырья
и
продуктов
животного
происхождения.
Материал направляют в лабораторию ООИ ФБУЗ «ЦГиЭ» в
субъекте РФ или в Региональный центр по мониторингу за
возбудителями
инфекционных
болезней
I-II
групп
патогенности или Центр индикации и диагностики опасных
инфекционных болезней (противочумное учреждение).
Лабораторные исследования продовольственного сырья и
продуктов
животного
происхождения
проводят
в
бактериологических лабораториях ветеринарной службы.
115.
Лаборатории территориального уровняЛаборатории ООИ ФБУЗ «ЦГиЭ» в субъекте
Российской Федерации проводят:
отбор материала из объектов окружающей среды
(почва, трава, фураж, подстилка, вода и т.д.),
продовольственного сырья и продуктов животного
происхождения - по эпидпоказаниям;
исследование материала от больных и умерших с
подозрением на сибирскую язву;
исследование материала из объектов окружающей
среды, продовольственного сырья и продуктов
животного происхождения;
116.
Лаборатории ООИ ФБУЗ «ЦГиЭ» в субъекте Российской Федерациипроводят:
Идентификацию штаммов возбудителя сибирской язвы основными
методами схемы идентификации культур согласно действующим
методическим указаниям по лабораторной диагностике сибирской
язвы.
Для подтверждения и дальнейшего изучения культуры направляют в
Региональный центр по мониторингу за возбудителями инфекционных
болезней I-II группы патогенности или Центр индикации и диагностики
опасных инфекционных болезней. Срок доставки – 5 суток.
Лабораторий Региональных центров по мониторингу за возбудителями
инфекционных и паразитарных болезней II-IV групп патогенности,
курирующих субъекты РФ и Центров индикации и диагностики
возбудителей опасных инфекционных болезней
исследование материала от больных и умерших с подозрением на
сибирскую язву;
забор и исследование материала из объектов окружающей среды,
продовольственного сырья и продуктов животного происхождения;
идентификацию штаммов возбудителя сибирской язвы основными
методами схемы идентификации.
117.
Лаборатории регионального уровняI этап
1) Прием, сортировка, регистрация проб, первичная обработка и подготовка их к
исследованию бактериологическим и биологическим методами.
2) Подготовка проб к исследованию методом ПЦР. Постановка ПЦР с пробами из
нативного материала.
3) Приготовление из подготовленных проб мазков для световой (окраска по Граму,
на обнаружение капсулы – по Ребигеру и спор – по Цилю-Нильсену) и
люминесцентной микроскопии.
4) Постановка МФА с пробами из нативного материала с окрашиванием мазков
иммуноглобулинами флуоресцирующими сибиреязвенными споровыми (пробы
из объектов окружающей среды) или иммуноглобулинами флуоресцирующими
сибиреязвенными соматическими (пробы от больных и секционного материала).
5) Подготовка проб из объектов окружающей среды для селективного
концентрирования на МИС с последующей постановкой ИФА.
6) Постановка ИХ-теста для выявления спор возбудителя сибирской язвы в пробах
из объектов окружающей среды.
7) Постановка
РНГА
с
антительным
диагностикумом
для
выявления
специфических антигенов в пробах из объектов окружающей среды.
8) Постановка РНГА с антигенным диагностикумом для выявления специфических
антител в крови больного.
9) Посев материала на питательные среды (агар и бульон Хоттингера или мясопептонные бульон и агар, селективная дифференциально-диагностическая
среда, 5 % кровяной агар).
10) Заражение биопробных животных.
118.
II этап2 ч от начала исследования: Учет результатов ИХ-теста - 4-6 ч от начала
исследования: Учет результатов бактериоскопии, МФА, РНГА.
8-10 ч от начала исследования: Учет результатов ПЦР.
Выдача предварительного положительного ответа специфической
индикации на основании результатов бактериоскопии, МФА, ИХ-теста,
ИФА, РНГА ПЦР.
III этап
18 ч от начала исследования: Просмотр посевов на плотных и жидких
питательных средах. Постановка теста на щелочную фосфатазу при
наличии
на
селективной
дифференциально-диагностической
питательной средой подозрительных шероховатых колоний
Постановка ИХ-теста для идентификации вегетативных клеток
возбудителя сибирской язвы на плотных и в жидких питательных
средах.
Отбор сходных по морфологии с возбудителем сибирской язвы
колоний с агара Хоттингера, МПА, фосфатазанегативных шероховатых
колоний
с
селективной
дифференциально-диагностической
питательной среды, негемолитических шероховатых колоний с
кровяного агара, положительных в ИХ-тесте.
Приготовление и микроскопия мазков из подозрительных колоний и из
жидких питательных сред с характерным придонным ростом в окраске
по Граму и Ребигеру.
119.
III этап (продолжение)18 ч от начала исследования:
Отсев отобранных изолированных колоний на плотные неселективные
питательные среды для получения чистой культуры в вегетативной и
споровой форме.
Проведение ПЦР и МФА с материалом из подозрительных колоний и
из жидких питательных сред.
Наблюдение за биопробными животными, вскрытие павших, высевы
на агар Хоттингера, селективную дифференциально-диагностическую
среду, приготовление мазков-отпечатков из органов и постановка ПЦР
с суспензией из гомогената органов.
Микроскопия мазков от биопробных животных, окрашенных по
Ребигеру или Романовскому-Гимзе, с оценкой капсулообразования in
vivo.
24 ч от начала исследования:
Подтверждение предварительного ответа результатов специфической
индикации.
120.
IV этап36-48 ч от начала исследования: Просмотр посевов на плотных и
жидких питательных средах. Работа аналогично 18 ч. от начала
исследований.
Оценка роста культуры и образование спор на плотных питательных
средах путем приготовления мазков, окрашенных по Цилю-Нельсену.
Постановка РЛА со споровой культурой.
Отсев чистых культур на скошенный агар для хранения и постановки
основных идентификационных тестов :
Проведение ПЦР и МФА с материалом из чистых культур.
48 ч от начала исследования: Выдача окончательного положительного
ответа по результатам специфической индикации, ускоренной
идентификации.
3-9 сутки от начала исследования: Выполнение пунктов IV этапа.
10 сутки от начала исследования: Если по истечении 72 ч
положительные
результаты
не
получены,
окончательное
отрицательное заключение может быть сделано не ранее 10 сут после
заражения биопробных животных при наличии отрицательных
результатов биологической пробы.
В случае гибели биопробных животных на 6-9 день после заражения
сроки исследования могут быть продлены.
121. Основные идентификационные тесты
IV этапоценка характера роста и определение чувствительности к
антибиотикам - высев в МПБ, бульон Хоттингера
определения капсулообразования in vitro – высев на
бикарбонатно-сывороточный агар
теста на щелочную фосфатазу – посев на селективную
дифференциально-диагностическую среду или на агар
Хоттингера
с
фенолфталеинфосфатом
натрия
(паранитрофенилфосфатом натрия)
тест на гемолиз – посев на 5 % кровяной агар
определение подвижности высев в полужидкий агар
постановка и учет теста «жемчужного ожерелья»
проба с бактериофагом
тест на желатиназу - посев на желатин
определение патогенности и капсулообразования in vivo.
122. Лаборатории регионального уровня
Информация об отборе проб, поступлении материала ивыделенных
или
идентифицированных
штаммах
передается в Референс-Центр по мониторингу за
возбудителем сибирской язвы и Национальный центр
верификации
диагностической
деятельности
Роспотребнадзора,
осуществляющий
функцию
Государственной коллекции возбудителей ООБИ I-II групп
патогенности.
Штаммы, выделенные от людей, из объектов окружающей
среды и идентифицированные в Региональных центрах или
Центрах индикации и диагностики, направляют в Референсцентр по мониторингу за возбудителем сибирской язвы.
Заключение
о
результатах
идентификации
штамма
направляют в учреждение, из которого штамм получен.
123. Лаборатории федерального уровня
Референс-центра по мониторингу за возбудителем сибирскойязвы
Исследование штаммов, полученные из региональных
лабораторий, в т.ч. с атипичными свойствами:
1)полная
идентификация
и
изучение
биологических,
молекулярно-генетических, биохимических свойств штаммов;
2)определение чувствительности штаммов к антибактериальным
препаратам;
3)генетическое типирование и секвенирование ДНК штаммов.
Исследование клинического (секционного), биологического
материала,
проб пищевых продуктов и образцов из
окружающей среды по эпидемиологическим показаниям с
учетом
сложившейся
эпизоотолого-эпидемиологической
обстановки.
124. Лаборатории федерального уровня
Идентификация по полной схемеТесты, проводимые в лабораториях регионального уровня +
1)определение лецитиназной активности;
2)определение протеолитической активности в отношении казеина и
альбумина;
3)определение гемолитической активности в отношении отмытых
эритроцитов барана;
4)определение способности к росту на минимал. синтетической среде;
5)определение вирулентности in vivo;
6)определение вирулентности in vitro (сочетанное определение капсуло- и
токсинообразования) ;
7)тест на патогенность для белых мышей и морских свинок;
8)определение вирулентности in vivo (LD50 и DCL);
9)определение специфичных продуктов ДНК плазмидной и хромосомной
локализации;
10)определение генотипа методами MLVA, SNP-, SNR-анализа и др.;
11) секвенирование ДНК выделенных штаммов.
125. Лаборатории федерального уровня
Лаборатории Национального центра верификациидиагностической деятельности
1)верификация результатов диагностики сибирской
язвы и идентификации штаммов, полученных из
Региональных
центров
по
мониторингу
за
возбудителями инфекционных болезней I-II групп
патогенности, Центров индикации и диагностики
опасных инфекционных болезней, Референс-центра по
мониторингу за сибирской язвой;
2)диагностические
исследования
материала
от
больных сибирской язвой и умерших от этой болезни;
3)хранение коллекционных штаммов, охраноспособное
и авторское депонирование.
126.
Лечение.Этиотропное – антибиотики + протвосибиреязвенный
иммуноглобулин (гамма-глобулин).
Кожная форма: Пенициллин в/м 12-24-36 млн в сут. – 14-21 дн.
Гентамицин в/м 0.16 х 2-3 раза/сутки – 10 дней
Ципрофлоксацин в/в 0.2 х 2 раза/сутки – 10 дней
Ингаляционная форма: Ципрофлоксацин в/в по 500 мг 2 раза
/сутки или доксициклин 100 мг 2 раза/сутки и один или два
дополнительных антибиотика. Начинают с в/в введения. Далее
– по обстоятельствам. Продолжительность – 6 суток.
При септической форме: цефалоспорины (4-6 г/сут),
левомицетина сукцинат (3-4 г/сут), гентамицин (24-320 мг/сут).
ИГ при л.ст. – 20 мл, ср.ст. – 40-80 мл. 3-5 дней.
Курсовая доза – до 400 мл.
Дезинтоксикацинная – растворы, плазмоферез, гемосорбция.
Патогенетическая – плазма, альбумин, стероиды.
127.
В США следующие схемы:- Cipro 400 мг х 2 раза в сут (14 дней), или доксициклин по 100 мг х 2 раза в сут.(12 - 60дней).
При заражении «боевым штаммом» (бакоружие): от 2-3
до 5 аньтибиотиклв, где 2-3 – резервные.
Профилактика.
1) Ветеринарный надзор.
2) Вакцинация людей из групп риска вакциной СТИ. В
США вакцина SC с ревакцинациями (0,2,4,6,12,18
мес).
3) Контактных с больными (животными или людьми) –
изоляция и наблюдение 2 нед.
4) Дезинфекция и пр..
128.
В настоящее время известны вакцины 4 типов:1) Живая – высушенные споры авирулентных бескапсульных
штаммов (Стерна, СТИ, ГНКИ).
2) Химическая (молекулярная) – сорбированный на носителе
протективный антиген (Райт).
3) Комбинированная – смесь спор и протективного антигена.
4) Рекомбинантная – генноинженерная.
Экстренная
профилактика
(соприкасавшимся
с
заразным
материалом,
приготовлении
и
употреблении
пищи
из
инфицированного мяса) – не позже 5 суток после предполагаемого
инфицирования – феноксиметилпенициллин или тетрациклин или
доксициклин в теч. 5 дн.
Местно – открытый метод. Хирургическое вмешательство
приводит к генерализации инфекции.
Госпитализация в отдельную палату, текущая дезинфекция,
перевязочный материал сжигают.
129.
Вакцины против сибирской язвы1990 г. – вакцина живая из штамма "55-ВНИИВВиМ" против сибирской
язвы животных лиофилизированная.
Вакцины, разработанные в последнее время
жидкая и сухая комбинированная сибиреязвенная вакцина на
основе протективного антигена (ПА) и спор штамма СТИ-1.
антибиотикоустойчивая вакцина СТИ-ПР для одновременной
специфической и экстренной профилактики.
Сибиреязвенными вакцинами нового поколения могут стать ДНК –
вакцины.
Карантин снимается по истечении 15 дней со дня
последнего случая падежа или выздоровления
животного, больного сибирской язвой, при
отсутствии у животных осложнений после
вакцинации.
130. Карантин при сибирской язве
Шлагбаум с дезинфекционнымбарьером и круглосуточной
охраной при въезде в очаг
сибирской язвы (2009 г.)
ДЕЗИНФЕКЦИЯ
Обработка машин,
выезжающих из карантинной
зоны, спороцидным препаратом
(2009 г.)
131. Дезинфектанты для обеззараживания загрязненных поверхностей при сибирской язве
Хлорсодержащие: кальция гипохлорит нейтральный (ГКН), известьбелильная термостойкая (хлорная известь), двуосновная соль
гипохлорита кальция, Тепсихлор 70А, хлорамин Б (активированные
растворы), ДП-2 (порошок), Клорсепт (таблетки).
Кислородсодержащие: перекись водорода, перекись водорода с
0,5% моющего средства, средство ПВК, Дезоксон.
Альдегидсодержащие: формальдегид.
Композиционные средства на основе:
ЧАС и щелочей: РИК-Д (для х/б белья, защитной одежды, посуды);
ЧАС и спирта: «Велтолен», «Велтолен-экстра» и «Велтодез»
только при Т 50⁰С (для обеззараживания белья и посуды).
Методы обеззараживания почвенных очагов сибирской язвы:
механический
термический
химический
132.
До эры антибиотиков с успехом применяли в/в введениейода, неосальварсан. Под кожу – 5% пептон, лошадиную
сыворотку.
Говоря о вакцине против СЯ следует с огромной
благодарностью и почтением вспомнить подвиги таких
ученых как Роберт Кох, который рискуя своей жизнью и
жизнью своих близких работал в домашних условиях с
культурой бацилл СЯ.
А великий Луи Пастер трижды рисковал жизнью и
карьерой.
Во-первых, когда работал с культурой СЯ.
Во-вторых, когда защищая идею об ослаблении
патогенности бактерий в пылу оскорбил доктора Герена.
133.
Представляете картину:80-летний Герен бросается с кулаками на 60-летнего (парализованного
на половину) Пастера. Далее, Пастер был вызван на дуэль маститым
Жюль Гереном (помните БЦЖ?). Пастер нашел в себе силы принести
извинения, правда, в письменной форме.
В-третьих, когда плелись интриги вокруг Пастера и он перестал
посещать академию наук от него потребовали публичным
экспериментом доказать эффективность противосибиреязвенной
вакцины. На ферме Пуйи-ле-Фор в присутствии видных ученых,
сенаторов республики, представителей духовенства, нескольких сотен
фермеров и журналистов из Лондона он вакцинировал овец и др.
животных. Через 12 дней провел ревакцинацию. А 31 мая всем
животным была введена смертельная доза бацилл и привитым и
непривитым. 2 июня 1881 г все 24 овцы, которые были привиты, выжили
и даже не дали повышения температуры. В прессе тогда писали, что
полупорализованный
человек
совершил
чудо
сравнимое
с
евангельскими, библейскими сказками.

medicine
medicine








